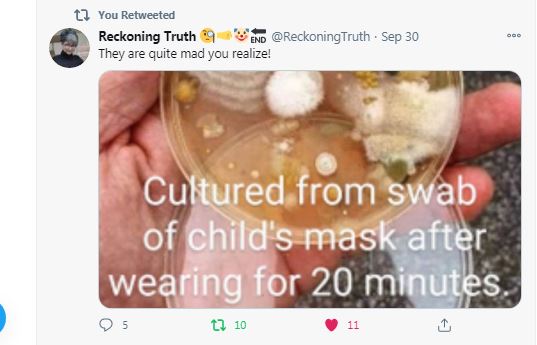

How to get URL link on X (Twitter) App
https://twitter.com/DanPriceSeattle/status/1329277596685709315

https://twitter.com/Penone10/status/1335266868391763973
https://twitter.com/Penone10/status/1336841177602121728


https://twitter.com/OnHels/status/1338876208080031744


https://twitter.com/Penone10/status/1341841141285740547



https://twitter.com/disclosetv/status/1343620091695538179
https://twitter.com/Penone10/status/1344082038123601920
https://twitter.com/Penone10/status/1344082038123601920
https://twitter.com/Penone10/status/1353909133288812547



https://twitter.com/RepThomasMassie/status/1356149384484945920
https://twitter.com/Penone10/status/1353909133288812547


https://twitter.com/678Hank/status/1369208845990518786


https://twitter.com/Penone10/status/1371331400142630913
https://twitter.com/Penone10/status/1371567163925012487



https://twitter.com/Penone10/status/1372415491692756992



https://twitter.com/dcexaminer/status/1372589804240596992
https://twitter.com/ReckoningTruth2/status/1379586967244042241
https://twitter.com/ReckoningTruth2/status/1380991193161609218

https://twitter.com/thesundaytimes/status/1386006834847363075
https://twitter.com/i/status/1389349863486369792



https://twitter.com/Penone10/status/1390870574495420420
https://twitter.com/Penone10/status/1355991950567071750
https://twitter.com/Penone10/status/1354690468051886086
https://twitter.com/GlennaWPLG/status/1384255418449371136
https://twitter.com/TrueNewsIsHere7/status/1395083528430362625


https://twitter.com/TrueNewsIsHere7/status/1401250153953214474
https://twitter.com/Penone10/status/1387952174374731776
https://twitter.com/TrueNewsIsHere7/status/1404921972845318144
https://twitter.com/realstewpeters/status/1407810090695118848



https://twitter.com/RealGeorgeWebb1/status/1413240016978038788








https://twitter.com/LivewithAndy/status/1469820920915271687
https://twitter.com/Kukicat7/status/1470144930253266945



https://twitter.com/PetrussssMax/status/1471939746754670605
https://twitter.com/btcKaz/status/1471165647359033355
https://twitter.com/ezralevant/status/1474106318206255113
https://twitter.com/solari_the/status/1473051254511312901
https://twitter.com/MythinformedMKE/status/1477091670424526852
https://twitter.com/MichaelPSenger/status/1477339192107560960



https://twitter.com/JannerDarren/status/1482609004463468550
https://twitter.com/Penone10/status/1487967273939787781
https://twitter.com/threadreaderapp/status/1492754256759345157






• • •
Keep Current with Inflection Point
Stay in touch and get notified when new unrolls are available from this author!
This Thread may be Removed Anytime!
Twitter may remove this content at anytime! Save it as PDF for later use!
@threadreaderapp unroll
Practice here first or read more on our help page!

https://twitter.com/Penone10/status/1353909133288812547







https://twitter.com/OnHels/status/1338876208080031744




Support us! We are indie developers!
This site is made by just two indie developers on a laptop doing marketing, support and development! Read more about the story.
Become a Premium Member ($3/month or $30/year) and get exclusive features!
Make a small donation by buying us coffee ($5) or help with server cost ($10)
Donate via PaypalOr Donate anonymously using crypto!
Ethereum
0xfe58350B80634f60Fa6Dc149a72b4DFbc17D341E
copy
Bitcoin
3ATGMxNzCUFzxpMCHL5sWSt4DVtS8UqXpi
copy
Thank you for your support!
Email the whole thread instead of just a link!